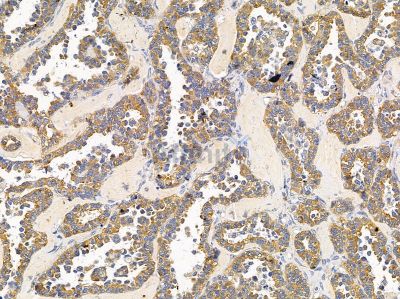
Валидация Affinity DF14650 - 10688

| UNIPROT | Q9Y6D6 |
| Иммуноген | Синтетический пептид, соответствующий human ARFGEF1 |
ARFGEF1 Antibody (DF14650)
Реактивность подтвержденная:
человек
Источник (хозяин):
кролик
Валидировано для:
IHC
Характеристики
Техническое описание
| Каталожный номер | DF14650 |
| Название антигена | ADP Ribosylation Factor Guanine Nucleotide Exchange Factor 1 (ARFGEF1) |
| UNIPROT | Q9Y6D6 |
| Иммуноген | Синтетический пептид, соответствующий human ARFGEF1 |
| Английские синонимы | P200, ARFGEP1, BIG1, Brefeldin A-inhibited guanine nucleotide-exchange protein 1, p200 ARF guanine nucleotide exchange factor |
Реактивность подтвержденная Нужна другая реактивность? |
человек |
| Источник (хозяин) | кролик |
| Изотип | IgG |
| Клональность | поликлональное |
| Рекомбинантное | нет |
| Готовое к использованию | нет |
| Концентрация | 1 мг/мл |
| Конъюгат | нет |
| Валидировано для | IHC Иммуногистохимия |
| Рекомендуемые разведения | IHC: 1:50-1:200; Оптимальное разведение определяется конечным потребителем |
| Метод очистки | Антисыворотку очищали методом аффинной хроматографии пептидов с использованием связывающей смолы SulfoLink® (Thermo Fisher Scientific) |
| Состав буфера | Rabbit IgG в PBS; pH 7.4; 150mM NaCl; 0.02% азид натрия и 50% глицерин |
| Условия доставки | Термобокс с аккумуляторами холода |
| Условия хранения | Хранить при -20ºС. Стабилен 12 месяцев с даты получения |
| Срок хранения | 12 месяцев |
| Производитель | Affinity |
| Ссылка на страницу товара на сайте производителя | https://www.affbiotech.com/goods-19094-DF14650-ARFGEF1_Antibody.html |
|
Артикул
|
Наименование |
Производитель
|
|---|
Акции и предложения
Популярные продукты:
Recombinant Human AFAP1 Protein, N-His (YHN28801)
Источник (хозяин): E.coli
Организм: человек
Фрагмент: Glu346-Ile478
Теги: N-His
Биоактивность: нет
Организм: человек
Фрагмент: Glu346-Ile478
Теги: N-His
Биоактивность: нет
Monoclonal Antibody to Amiloride Binding Protein 1 (ABP1) (MAA656Ra25)
Источник (хозяин): мышь
Реактивность подтвержденная: крыса
Валидировано для: WB
Реактивность подтвержденная: крыса
Валидировано для: WB
Guinea Pig Protein ADP ribosylarginine] hydrolase(ADPRH) ELISA kit (E05P0222)
Организм: морская свинка
Recombinant Human LR3-IGF-1 Protein (MG) (PKSH032712)
Источник (хозяин): E.coli
Организм: человек
Фрагмент: Gly49-Ala118
Теги: без тега
Биоактивность: нет
Организм: человек
Фрагмент: Gly49-Ala118
Теги: без тега
Биоактивность: нет